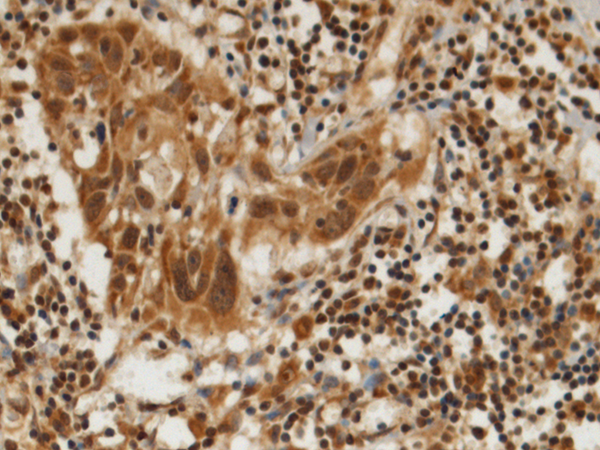

|
IHC Recommend dilution: |
100-300 |
|
IHC positive control: |
Human esophagus cancer and Human gastric cancer |
|
ELISA Recommended dilution: |
5000-10000 |
|
SwissProt: |
Q14562 |
|
Synonyms: |
DDX8; Dhr2; HRH1; PRP22; PRPF22 |
|
Full name: |
DEAH-box helicase 8 |
|
Immunogen: |
Fusion protein of human DHX8 |
|
Name of antibody: |
DHX8 |
|
Applications: |
ELISA, IHC |
|
Background: |
This gene is a member of the DEAH box polypeptide family. The encoded protein contains the DEAH (Asp-Glu-Ala-His) motif which is characteristic of all DEAH box proteins, and is thought to function as an ATP-dependent RNA helicase that regulates the release of spliced mRNAs from spliceosomes prior to their export from the nucleus. This protein may be required for the replication of human immunodeficiency virus type 1 (HIV-1). Alternative splicing results in multiple transcript variants. [provided by RefSeq, Oct 2014] |

購(gòu)物車
購(gòu)物車 幫助
幫助
 021-54845833/15800441009
021-54845833/15800441009
